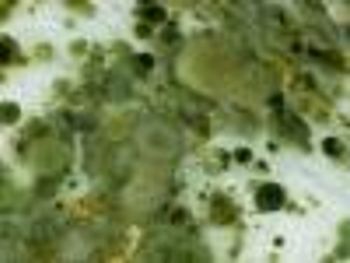

Lauren Santye, Assistant Editor
Articles by Lauren Santye, Assistant Editor

Stacey Ness, PharmD, RPh, CSP, MSCS, AAHIVP, senior director of Specialty Clinical Services at Managed Health Care Associates, discusses how specialty stakeholders will need to alter current patient management programs as new drugs transform the treatment of diseases into more manageable conditions.

Broadly neutralizing antibody delays viral rebound and opens doors for future HIV vaccines.

CD98 molecule could be a potential therapeutic target in AML.

Top news of the day from across the health care landscape.

A newly identified metabolic fingerprint of colorectal cancer may serve as a future diagnostic tool in early detection.

John Campo, vice president of Specialty Pharmacy Trade Relations and Contracting at Managed Health Care Associates, discusses optimal use of data analytics in specialty pharmacy.

Top news of the day from across the health care landscape.

Vietnam War veterans are more likely to contract hepatitis C virus than any other veterans, and 65-year-old Joe Benko was no exception to the statistic.

A veteran of the Vietnam War recounts the challenges of treatment for hepatitis C virus.

Recent findings suggest that calcium may play a role in the switch from acute to chronic lung infection from the bacterium Pseudomonas aeruginosa.

Interfering with energetic metabolism may stop glioblastoma growth and recurrence.

Rehabilitation with the help of the internet ameliorates life quality and side effects in women with breast cancer.

Top news of the day from across the health care landscape.

Despite individuals with diabetes having a higher risk of developing serious eye diseases, more than half skip out on their annual eye exams.

Findings may provide further knowledge of how patients end up developing HIV-1 associated nephropathy.

There are 40 million adults in the United States who smoke cigarettes, which accounts for an estimated 28.7% of all cancer deaths.

The proportion of cancer deaths attributable to smoking differs among states, but the highest proportion was seen in the Southern United States.

Top news of the day from across the health care landscape.

Sight-saving eye exam skipped by diabetes patients, despite increased risk of serious eye diseases.

After being denied bail, the Afghani refugee who donned the cover of National Geographic in the 1980s, was rushed to a local hospital in Pakistan.

A chemical inhibitor was found to limit the growth of lung tumor cells and may provide better treatment for lung cancer patients.

Rinku Patel, PharmD, RPh, founder and CEO of KloudScript, discusses the latest trends in the specialty pharmacy landscape.
Top news of the day from across the health care landscape.

Gene mapping tools identify a rare disease caused by ASXL2 gene mutation, which shares similarities to other rare genetic disorders.

Tumor markers can help guide future treatments for patients with bladder cancer.

A cell-editing platform allowed researchers to find genetic mutations that allow human immune cells to be resistant to HIV.

Top news of the day from across the health care landscape.

New findings reveal that individuals who follow the Mediterranean diet may decrease the risk of age-related macular degeneration (AMD) by more than one-third.

Newly-discovered compound blocks an essential protein in sustaining tumor growth.

A chronic lung infection from Pseudomonas aeruginosa can be drug-resistant and cause lung tissue damage.